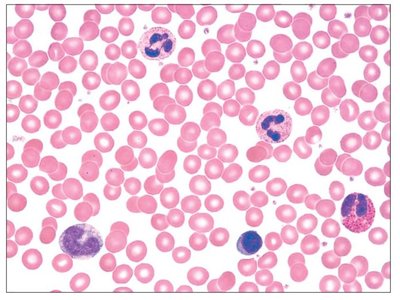
Blood smear showing erythrocytes, leukocytes, and platelets

BackBlood: Structure, Function, and Clinical Relevance
Study Guide - Smart Notes
Tailored notes based on your materials, expanded with key definitions, examples, and context.
Blood: Structure, Function, and Clinical Relevance
Introduction to Blood
Blood is a specialized connective tissue essential for transporting gases, nutrients, hormones, and waste products throughout the body. It also plays a critical role in immune defense, hemostasis, and homeostasis. Understanding the composition and function of blood is foundational for students in anatomy and physiology, especially those pursuing health-related careers.
Major Components of Whole Blood
Separation and Composition of Blood
Blood consists of two main components: plasma (the liquid matrix) and formed elements (cells and cell fragments). When blood is centrifuged, it separates into distinct layers:
Plasma: About 55% of whole blood; contains water, proteins, nutrients, hormones, and waste products.
Buffy coat: Less than 1% of whole blood; contains leukocytes (white blood cells) and platelets.
Erythrocytes: About 45% of whole blood; red blood cells responsible for oxygen transport.

Clinical Application: The relative proportions of these layers can indicate health or disease states (e.g., anemia, polycythemia).
Formed Elements of Blood
Types of Blood Cells
The formed elements include erythrocytes, leukocytes, and platelets. Each type has distinct morphology and function:
Erythrocytes (Red Blood Cells, RBCs): Biconcave, anucleate cells specialized for oxygen and carbon dioxide transport.
Leukocytes (White Blood Cells, WBCs): Spherical, nucleated cells involved in immune defense. Subdivided into granulocytes and agranulocytes.
Platelets (Thrombocytes): Small, disc-shaped cell fragments essential for blood clotting.
Structure of Erythrocytes
Erythrocytes are uniquely adapted for gas transport due to their biconcave shape, which increases surface area and flexibility. They lack nuclei and most organelles, maximizing space for hemoglobin.
Diameter: 7–8 μm
Thickness: 2.5 μm at thickest point
Function: Transport oxygen from lungs to tissues and carbon dioxide from tissues to lungs.

Leukocytes: Types and Functions
Classification of Leukocytes
Leukocytes are classified based on the presence or absence of cytoplasmic granules:
Granulocytes: Neutrophils, Eosinophils, Basophils
Agranulocytes: Lymphocytes, Monocytes
The relative percentages of each type are important for diagnosing infections and other disorders.

Granulocytes
Neutrophils: Multilobed nucleus, pale red and blue granules; phagocytize bacteria and are the most abundant WBC (50–70%).
Eosinophils: Bilobed nucleus, red granules; combat parasitic infections and modulate allergic responses (2–4%).
Basophils: Bilobed nucleus, purplish-black granules; release histamine and mediate inflammation (0.5–1%).

Agranulocytes
Lymphocytes: Large, spherical nucleus with thin rim of cytoplasm; mount immune responses by direct cell attack or via antibodies (25–45%).
Monocytes: Kidney-shaped nucleus, abundant pale blue cytoplasm; differentiate into macrophages for phagocytosis (3–8%).

Summary Table: Formed Elements of Blood
The following tables summarize the main characteristics, development, and functions of the formed elements of blood.
Cell Type | Description | Number per mm3 | Development & Life Span | Function |
|---|---|---|---|---|
Erythrocytes | Biconcave, anucleate; 7–8 μm | 4–6 million | D: 5–9 days LS: 100–120 days | Transport oxygen and carbon dioxide |
Neutrophils | Multilobed nucleus; pale granules | 3000–7000 | D: 7–11 days LS: 6 hours to a few days | Destroy bacteria by phagocytosis |
Eosinophils | Bilobed nucleus; red granules | 100–400 | D: 7–11 days LS: 5 days to a few weeks | Turn off allergic responses; kill parasites |
Basophils | Bilobed nucleus; large purple granules | 20–50 | D: 3–7 days LS: hours to a few days | Release histamine and mediate inflammation |

Cell Type | Description | Number per mm3 | Development & Life Span | Function |
|---|---|---|---|---|
Lymphocytes | Spherical or indented nucleus; pale blue cytoplasm | 1500–3000 | D: days to weeks LS: hours to years | Mount immune response via direct attack or antibodies |
Monocytes | U- or kidney-shaped nucleus; gray-blue cytoplasm | 100–700 | D: 2–3 days LS: months | Phagocytosis; develop into macrophages |
Platelets | Discoid cytoplasmic fragments; purple granules | 150,000–500,000 | D: 4–5 days LS: 5–10 days | Seal small tears in blood vessels; blood clotting |

Hematopoiesis: Blood Cell Formation
Red Bone Marrow
Blood cells are produced in red bone marrow, which is found within the trabeculae of spongy bone. Hematopoietic stem cells in the marrow give rise to all formed elements through a process called hematopoiesis.
Location: Spongy bone of axial skeleton, girdles, and proximal epiphyses of humerus and femur.
Structure: Contains blood sinusoids, adipocytes, reticular fibers, and developing blood cells.

Clinical Scenario: Blood and Bruising
Case Study: Petechiae and Thrombocytopenia
Scenario: A child presents with petechiae (tiny red-purple spots), unexplained bruising, and a prolonged nosebleed. Lab results show a low platelet count but normal white blood cell count.
Diagnosis: Thrombocytopenia (low platelet count), possibly post-viral immune thrombocytopenic purpura (ITP).
Management: Observation for mild cases; corticosteroids or intravenous immunoglobulin (IVIG) for severe cases.
Key Concept: Platelets are essential for blood clotting; their deficiency leads to increased bleeding and bruising.
Key Terms and Concepts
Hematocrit: Percentage of blood volume occupied by erythrocytes.
Hemoglobin: Oxygen-carrying protein in erythrocytes.
Leukocytosis: Elevated white blood cell count, often indicating infection.
Thrombocytopenia: Low platelet count, leading to bleeding risk.
Summary
Blood is a vital tissue composed of plasma and formed elements, each with specialized functions. Understanding the structure, function, and clinical significance of blood components is crucial for health professionals and students of anatomy and physiology.